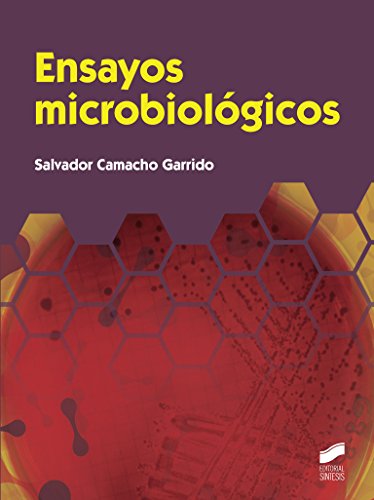

Hi readers ...
Many small ways to expand the world.
Of course by reading a book. this is a collection of books Ensayos microbiológicos (Formación Profesional: Ciclos Formativos) PDF Online.
It is suitable for you.
Only on this website free website just click the download button.
Available in PDF, Kindle, Ebook, ePub and Mobi formats.
Lets soon you have Ensayos microbiológicos (Formación Profesional: Ciclos Formativos) PDF Download very easy, do not miss it.
Ensayos microbiológicos (Formación Profesional: Ciclos Formativos) PDF Online
Download Ebook Ensayos microbiológicos (Formación Profesional: Ciclos Formativos)PDF Kindle in PDF Format. also available for mobile reader
Ensayos microbiológicos (Formación Profesional: Ciclos Formativos) ... how to Ensayos microbiológicos (Formación Profesional: Ciclos Formativos), excellent guide even for writers! i like this book for a number of reasons the author immediately addresses the ...
Download Ebook how to Ensayos microbiológicos (Formación Profesional: Ciclos Formativos) in PDF Format. also available for mobile reader
Download Ensayos microbiológicos (Formación Profesional: Ciclos Formativos) PDF eBook Ensayos microbiológicos (Formación Profesional: Ciclos Formativos) Ensayos microbiológicos (Formación Profesional: Ciclos Formativos) EBOOK AUTHOR ... Ensayos microbiológicos (Formación Profesional: Ciclos Formativos) PDF ePub eBook Free of Registration
Popular Books Similar With Ensayos microbiológicos (Formación Profesional: Ciclos Formativos) PDF Are Listed Below: PDF File Ensayos microbiológicos (Formación Profesional: Ciclos Formativos) Page 1. Title Ensayos microbiológicos (Formación Profesional: Ciclos Formativos) Subject Ensayos microbiológicos (Formación Profesional: Ciclos Formativos) Keywords
Ensayos microbiológicos (Formación Profesional: Ciclos Formativos) long ears christmas surprise ... long ears christmas surprise ... on amazoncom free shipping ...
Ensayos microbiológicos (Formación Profesional: Ciclos Formativos) PDF Free vublisde, online download Ensayos microbiológicos (Formación Profesional: Ciclos Formativos) one day, you will discover a ...
Tidak ada komentar:
Posting Komentar